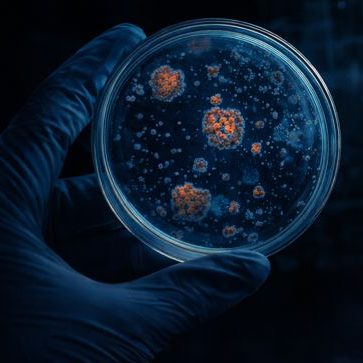

Sauberes Trinkwasser & sichere Anlagen – zuverlässig geprüft
Ihr ETL-Service für Entkalkung, Trinkwasserhygiene und Legionellenprüfung – schnell und fachgerecht.
Haben Sie Probleme mit Ihrer Anlage?
✔ Lange Aufheizzeiten oder hohe Energiekosten
✔ Kalkablagerungen in Leitungen oder Geräten
✔ Verfärbtes oder unangenehmes Wasser
✔ Unsicherheit bei der Legionellenprüfung
Wir sorgen für klare Ergebnisse und sichere Lösungen.

✔ Spezialisierung auf Trinkwasser- und Heizungsanlagen
✔ Erfahrung in Wohn- und Gewerbeobjekten
✔ Schnelle Terminvergabe
✔ Persönlicher & direkter Service

Professionelle Entkalkungsdienste für Trinkwasser- & Warmwassersysteme
Effektive Entkalkung für saubere Leitungen, zuverlässige Warmwasserleistung und geringere Energiekosten – fachgerecht, schonend und normkonform.
✔ Entkalkung von Elektro-Boilern & Warmwasserspeichern
✔ Entkalkung von Trinkwassererwärmern, Hygienestationen & Wärmetauschern
✔ Chemische & mechanische Entkalkung – abgestimmt auf Anlagentyp und Verschmutzungsgrad
✔ Entfernung von Kalk, Ablagerungen & Rückständen aus wasserführenden Systemen
✔ Austausch von Dichtungen, Opferanoden & Verschleißteilen bei Bedarf
Professionelle Trinkwasserhygiene für Gebäude & Anlagen
Sauberes Trinkwasser, hygienisch einwandfreie Leitungen und maximale Betriebssicherheit – fachgerecht umgesetzt nach bewährten Hygienestandards.
✔ Reinigung & Desinfektion von Trinkwasseranlagen
✔ Entfernung von Ablagerungen, Biofilmen & Verunreinigungen aus Leitungen
✔ Dichtmittelbehandlung an Heizungsleitungen zur Vermeidung von Sauerstoffeintrag
✔ Reinigung von Fußbodenheizungs- & Heizungsleitungen
✔ Rundum-Befüll-Service für Heizungs- & Solaranlagen
✔ Druckproben an Trinkwasser- & Heizungsanlagen
Legionellentest & Probenahme-Service (ab April 2026)
Zuverlässige Legionellenprüfung für sichere Trinkwasserqualität und rechtssichere Dokumentation – fachgerecht und normkonform durchgeführt.
✔ Legionellenprüfung in Mehrfamilienhäusern & Großwohnanlagen
✔ Fachgerechte Probenahme an relevanten Entnahmestellen
✔ Dokumentation & Terminierung mit benötigten Wohneinheiten und Hausverwaltung
✔ Aufbereitung der Unterlagen für das Gesundheitsamt
✔ Probenahmen auch abends möglich
Hilfsservice für Bautrocknung & Schadensanierung
Zuverlässige technische Unterstützung für Bautrocknungsfirmen, Sanierer und Handwerksbetriebe – schnell, flexibel und fachgerecht.
✔ Dichtmittelservice an Heizungsanlagen
✔ Provisorischer Notreparaturservice bei Leckagen
✔ Nachfüllservice von Heizungsanlagen mit VE-Wasser nach Prüfungen
✔ Rohrleitungsreinigung nach Prüfungen an wasserführenden Leitungen
✔ Langzeit-Druckproben an Wasser- & Heizungsanlagen
✔ Druckproben an Fußbodenheizungs-Verteilern

täglich neue
Zufriedene Kunden
12
Jahre Erfahrung im SHK-Bereich
>100
Durchgeführte Tests
ETL Service – Spezialist für Trinkwasser- & Heizungsanlagen in Bayern
Saubere Technik. Sichere Wasserqualität. Nachhaltige Lösungen.
Wir unterstützen Privatkunden, Vermieter, Hausverwaltungen und Gewerbebetriebe bei der professionellen Instandhaltung und Optimierung ihrer wasserführenden Systeme – zuverlässig, normkonform und effizient.
Unsere Leistungen im Überblick
🔹 Entkalkung von Trinkwasser- & Warmwassersystemen
Wir entfernen Kalkablagerungen fachgerecht und stellen die ursprüngliche Leistungsfähigkeit Ihrer Anlage wieder her – für geringere Energiekosten und längere Lebensdauer.
🔹 Trinkwasserhygiene
Reinigung und Desinfektion von Leitungen und Anlagen zur Sicherstellung hygienisch einwandfreier Wasserqualität – Schutz für Bewohner und Betreiber.
🔹 Legionellentests & Probenahme
Fachgerechte Probenahme, Laboranalyse und rechtssichere Dokumentation gemäß gesetzlichen Vorgaben.
🔹 Technischer Hilfsservice für Bautrocknung & Sanierung
Warum Kunden auf ETL-Service vertrauen
✔ Spezialisierung auf Trinkwasser- und Heizungsanlagen
✔ Erfahrung mit Mehrfamilienhäusern & Gewerbeobjekten
✔ Dokumentierte und normgerechte Durchführung
✔ Transparente Beratung & faire Preisstruktur
✔ Schnelle Terminvergabe in Bayern
Alles aus einer Hand – fachgerecht, zuverlässig und lösungsorientiert.
Senden Sie uns eine Anfrage
Wir melden uns in der Regel innerhalb von 24 Stunden zurück.
✔ Fachgerechte Durchführung
✔ Regionale Betreuung
✔ Schnelle Terminvergabe
✔ Persönlicher Ansprechpartner
Sie möchten lieber direkt sprechen?
☎ Büro: 08082/6039105
📱 Mobil: +49 152 09446262
ETL-Service Entkalkung, Trinkwasserhygiene und Legionellentest Service
Pappenhaimstr. 16A
84419 Schwindegg